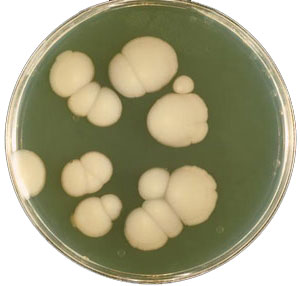
Чим небезпечний кандидоз під час вагітності?

Вагітна жінка поєднує в собі два чудових прекрасних світи – власний і малюка, якого виховує багато місяців під серцем, в собі. Коли дитина зростає у «внутрішньому просторі» жінки - змінюється її стан, настрій, уподобання.
Змінюється і стану її тіла – лінії стають більш обтічні, м'які і ще більш красиві.
Одна моя вагітна подруга ставала біля дзеркала і дивлячись на свій животик, гладила його і говорила «Яка я прекрасна. Яке це щастя, що нас зараз двоє – неповторні миті мого життя». Я посміхалася і думала «Так. Це так».
1. Які метаморфози відбуваються з майбутньою мамою під час вагітності?

Вагітність – це не захворювання, а нормальний фізіологічний процес. Звичайно ж, жінка змінюється і трохи по-іншому під час вагітності відчуває себе, тіло. Іноді з'являється важкість в ногах, втома, задишка, важкість у животі; можливі неприємні виділення.
Такі ситуації повинні наштовхнути на НЕГАЙНЕ звернення до гінеколога. Щоб зберегти власне здоров'я і скарб всередині Вас. Виділення та зуд (кольпіт) можуть виникнути не тільки при молочниці (кандидозі), але і при багатьох інших інфекціях. Враховуючи це, ставити собі діагноз без обстежень у лікаря і починати самолікування, звичайно ж, - не МОЖНА. Ви зобов'язані піти до гінеколога і виявити конкретного збудника, щоб розуміти, що з вами, що очікувати і що робити.
2. Якщо ваш діагноз «Кандидоз», то - це значить....?
Винуватці захворювання – це дріжджоподібні гриби роду Сandida.
Діагноз ґрунтується на даних анамнезу, результатах імунологічних, бактеріологічних і загальноклінічних методів обстежень (неприємний запах, виділення білого кольору (схожі на сир) з піхви, відчуття печіння та/або свербежу зовнішніх органів статевої системи, можлива біль під час статевого акту, або/і (не виключено) хворобливе сечовипускання. Вперше крихітці трапляється стикнутися з грибами роду Candida протягом першого року життя, а також - внутрішньоутробно.
3. Наскільки небезпечний кандидоз для вагітної? Для дитини?
Не можна "молочницю" вважати нормальним і безпечним супутником вагітності, як вважають деякі жінки.
Ризик, пов'язаний з грибком, полягає поруч з іншими ризиками, наприклад:
- ризик інфікування плода та навколоплідних оболонок (амніонит, хоріоамніонит);
- ризик появи внутрішньоматкового кисневого голодування плоду;
- ризик пологів, раніше, ніж встановлений термін;
- ризик народження дитини з низькою масою тіла;
- можливе передчасне вилиття навколоплідних вод;
- ризик виникнення у матері ранової післяпологової інфекції (такий як, наприклад, ендометрит)
- ризик мимовільного викидня;
- ризик інфікування шкіри та/або слизових оболонок, внутрішніх органів, у тому числі, легких малятка.
4. І чому «Ми» захворіли? Які можливі причини виникнення кандидозу у майбутньої мами?
Зростання дріжджоподібних грибів - Candida може посилюватися при вагітності. При статевому контакті відсоток зараження - дуже невеликий, але тут важливими моментами є, наприклад, травма статевих органів, яка може запустити у схильній до даної проблеми жінки, мікоз. При фізіологічному (і середньостатистичному) зниження клітинного імунітету, який часто буває у вагітних жінок, а також високій рівень глікогену - створюють сприятливе середовище для розмноження і росту дріжджоподібних грибів.
Важливу роль відіграють шкідливі звички (куріння, алкоголь, та інші). А також – спосіб життя (наприклад, гіподинамія).

Також причинами можуть бути:
- гіпотеріоз,
- гіпопаратиреоз,
- порушення вуглеводного обміну (або надлишок вживання солодкого),
- зниженням функції підшлункової залози,
- порушення кровопостачання кінцівок (коли малюк починає рости і матка збільшується і може тиснути на судини),
- алергічні зміни стінок судин органів і тканин,
- гіпо-і авітаміноз,
- дисбактеріоз,
- функціональні порушення вегетативної нервової системи,
- гормональними змінами (зростання рівня жіночих гормонів статевої сфери, таких як прогестерон.) Це речовина, вкрай важлива, тому що робить можливим процес вагітності – але і крім цього, створює досить помітний імуносупресивний ефект. Безумовно, серйозну роль у появі і розвитку інфекції також відіграє зміна слизової піхви (знову ж таки - через зміни гормональні).
- хвороби обміну речовин, травматичні ушкодження шкірних покривів або слизових оболонок при виражено динамічному статевому акті.
- проблеми з шлунком, кишечником (порушення всмоктування вітамінів або мінералів),
- хронічні захворювання, в стадії суб - або декомпенсації,
- онкопроблеми - вони додатково знижують імунітет.
- довготривалий прийом ліків, таких як антибіотики кортикостероїди.
Якщо вагітна в 40 тижнів або раніше мала латентну стадію або так сталося, що стала носієм даного збудника в тридцяти відсотках випадків - можлива колонізація грибами вагінально. Ті, у кого в родових шляхах живуть колонії лактобактерій - не схильні до появи симптоматики кандидозних вагінітів за рахунок продукування перекису водню цієї флорою.
5. Коли малюк може захворіти?

Зараження плода підтверджується визначенням Сandida в навколоплідній рідині, а також у плаценті і в оболонках пуповини. Поселення грибів у малюків можливе при народженні - в самих родових шляхах; або при контакті зі слизовою оболонкою рота дитини під час годування, або з шкірою рук, продуктами харчування, домашніми предметами.
6. Як лікувати? Що робити?
Визначити правильний спосіб лікування, враховуючи індивідуальні особливості конкретно вагітної жінки ПОВИНЕН ВАШ ГІНЕКОЛОГ, можливо навіть з іншими фахівцями. У таких випадках дивляться на можливу алергію, хронічні захворювання та інші патології; особливості перебігу Вашої вагітності, для того, щоб лікування кандидозу було комплексним, ступінчастим, з метою ліквідації гриба і повне усунення інших, що привертають до цього чинників, наприклад, лікування супутніх проблем.
7. Хочу попередити цю ситуацію. Але як?
Важливі способи попередження захворювання грибами під час вагітності – це обов'язково – утримання від небезпечних звичок. Перед планованою вагітністю – санація хронічних вогнищ інфекцій та обстеження. До, і під час, і після пологів - особиста гігієна, (в тому числі - білизна, що не тисне, краще всього з бавовни), правильне харчування, активний спосіб життя (після порад від гінеколога, крізь призму ваших супутніх захворювань) і серйозний підхід з метою ОБОВ'ЯЗКОВОГО та РЕГУЛЯРНОГО спостереження лікаря, якому ви довіряєте.
